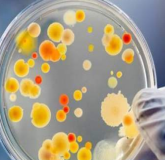
image.png

人体内的细胞(生物有机体、微生物、病原体、细菌、免疫系统...)简单介绍
名称 |
介绍 |
图谱 |
生物 |
(英语:Organism,又称生命体、有机体)是有生命的个体。生物较重要和基本的特征在于生物进行新陈代谢及遗传。所有生物一定会具备合成代谢以及分解代谢,这是互相相反的两个过程,并且可以繁殖下去, 这是生命现象的基础。自然界是由生物和非生物的物质和能量组成的。有生命特征的有机体叫做生物,无生命的包括物质和能量叫做非生物。(注:新陈代谢是生物与非生物本质的区别。) |
|
有机体 |
是具有生命的个体的统称,包括植物和动物,例如低等、原始的单细胞生物,高等、复杂的人类。 |
|
细胞 |
是生物体基本的结构和功能单位。已知除病毒之外的所有生物均由细胞所组成,但病毒生命活动也必须在细胞中才能体现。 一般来说,细菌等绝大部分微生物以及原生动物由一个细胞组成,即单细胞生物,高等植物与高等动物则是多细胞生物。 |
|
微生物 |
是个体难以用肉眼观察的一切微小生物。 微生物包括:细菌、病毒、真菌以及一些小型的原生生物、显微藻类等在内的一大类生物群体, 将微生物划分为以下8大类:细菌、病毒、真菌、放线菌、立克次氏体、支原体、衣原体、螺旋体。有些微生物是肉眼可以看见的,像属于真菌的蘑菇、灵芝、香菇等。还有微生物是一类由核酸和蛋白质等少数几种成分组成的"非细胞生物",但是它的生存必须依赖于活细胞。 |
|
病原体 |
病原体(pathogens)指可造成人或动植物感染疾病的微生物(包括细菌、病毒、立克次氏体、真菌)、寄生虫或其他媒介(微生物重组体包括杂交体或突变体)。 病原体(pathogen)能引起疾病的微生物和寄生虫的统称。微生物占绝大多数,包括病毒、衣原体、立克次体、支原体、细菌、螺旋体和真菌;寄生虫主要有原虫和嚅虫。病原体属于寄生性生物,所寄生的自然宿主为动植物和人。能感染人的微生物超过400种,它们广泛存在于人的口、鼻、咽、消化道、泌尿生殖道以及皮肤中。 |
|
细菌 |
广义的细菌即为原核生物。是指一大类细胞核无核膜包裹,只存在称作拟核区的裸露DNA的原始单细胞生物,包括真细菌和古生菌两大类群。
通常所说即为狭义的细菌,狭义的细菌为原核微生物的一类,是一类形状细短,结构简单,多以二分裂方式进行繁殖的原核生物,是在自然界分布较广、个体数量较多的有机体,是大自然物质循环的主要参与者。
细菌也对人类活动有很大的影响。一方面,细菌是许多疾病的病原体,包括肺结核、淋病、炭疽病、梅毒、鼠疫、砂眼等疾病都是由细菌所引发。然而,人类也时常利用细菌,例如乳酪及酸奶的制作、部分抗生素的制造、废水的处理等,都与细菌有关。在生物科技领域中,细菌有也著广泛的运用。 |
|
真菌 |
真菌(Fungis)是一类真核生物。较常见的真菌是各类蕈类,另外真菌也包括霉菌和酵母。现在已经发现了七万多种真菌,估计只是所有存在的一小半。真菌自成一门,和植物、动物和细菌相区别。真菌和其他三种生物较大的不同之处在于,真菌的细胞有含甲壳素(又叫几丁质、甲壳素、壳多糖)为主要成分的细胞壁,和植物的细胞壁主要是由纤维素组成的不同。 真菌门,分为鞭毛菌亚门、接合菌亚门、子囊菌亚门、担子菌亚门和半知菌亚门。其中,担子菌亚门是一群多种多样的高等真菌,多数种具有食用和药用价值,如银耳、金针菇、竹荪、牛肝菌、灵芝等,但也有豹斑毒伞、马鞍、鬼笔蕈等有毒种。另外,半知菌亚门中约有300属是农作物和森林病害的病原菌,还有些属是能引起人类和一些动物皮肤病的病原菌,如稻瘟病菌,能引起苗瘟、节瘟和谷里瘟等。 |
|
病毒 |
病毒,是一类不具细胞结构,具有遗传、复制等生命特征的微生物。一般为球状病毒、杆状病毒和蝌蚪状病毒。 病毒同所有的生物一样,具有遗传、变异、进化的能力,是一种体积非常微小,结构**简单的生命形式,病毒有高度的寄生性,完全依赖宿主细胞的能量和代谢系统,获取生命活动所需的物质和能量,离开宿主细胞,它只是一个大化学分子,停止活动,可制成蛋白质结晶,为一个非生命体,遇到宿主细胞它会通过吸附、进入、复制、装配、释放子代病毒而显示**的生命体特征,所以病毒是介于生物与非生物的一种原始的生命体。 |
|
**细胞 |
**细胞,是一种变异的细胞,是产生**症的病源。**细胞与正常细胞不同,有无限增殖、可转化和易转移三大特点,能够无限增殖并破坏正常的细胞组织。 **细胞除了分裂失控外(能进行多极分裂),还会局部侵入周遭正常组织甚至经由体内循环系统或淋巴系统转移到身体其他部分。 |
|
免疫系统 |
免疫系统具有免疫监视、防御、调控的作用。这个系统由免疫器官(骨髓、脾脏、淋巴结、扁桃体、小肠集合淋巴结、阑尾、胸腺等)、免疫细胞(淋巴细胞、单核吞噬细胞、中性粒细胞、嗜碱粒细胞、嗜酸粒细胞、肥大细胞、血小板等),以及免疫活性物质(抗体、溶菌酶、补体、免疫球蛋白、干扰素、白细胞介素、**坏死因子等细胞因子)组成。免疫系统分为固有免疫(又称非特异性免疫)和适应免疫(又称特异性免疫),其中适应免疫又分为体液免疫和细胞免疫。 免疫系统(immune system)是机体执行免疫应答及免疫功能的重要系统。由免疫器官、免疫细胞和免疫分子组成。免疫系统具有识别和排除抗原性异物、与机体其他系统相互协调.共同维持机体内环境稳定和生理平衡的功能 。
免疫系统(immune system)是防卫病原体入侵较**的武器,它能发现并清除异物、外来病原微生物等引起内环境波动的因素。但其功能的亢进会对自身器官或组织产生伤害。 |
|
人体共有三道防线: |
1.防线:是由皮肤和黏膜构成的,
他们不仅能够阻挡病原体侵入人体,而且它们的分泌物(如乳酸、脂肪酸、胃酸和酶等)还有杀菌的作用。呼吸道黏膜上有纤毛,可以清除异物。
2.**道防线:是体液中的杀菌物质和吞噬细胞
这两道防线是人类在进化过程中逐渐建立起来的天然防御功能,特点是人人生来就有,不针对某一种特定的病原体,对多种病原体都有防御作用,因此叫做非特异性免疫(又称先天性免疫)多数情况下,这两道防线可以防止病原体对机体的侵袭。
3.第三道防线:主要由免疫器官(胸腺、淋巴结和脾脏等)和免疫细胞(淋巴细胞)组成。
第三道防线是人体在出生以后逐渐建立起来的后天防御功能,特点是出生后才产生的,只针对某一特定的病原体或异物起作用,因而叫做特异性免疫(又称后天性免疫)。 |
|

齐岳微信公众号
官方微信
库存查询